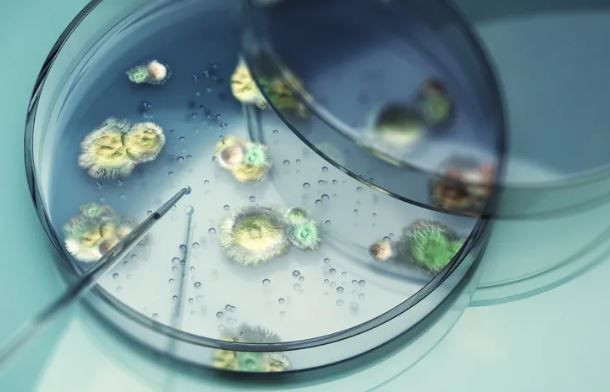
Kuzey İrlanda’da ürperten keşif: Örümcekleri zombiye dönüştürüyor - Resim: 4

Kuzey İrlanda’nın karanlık köşelerinde, doğanın en tuhaf ve korkutucu senaryolarından biri gerçek oldu. İrlanda’da keşfedilen yeni bir mantar türünün mağara örümceklerini davranışını değiştirerek ‘zombi’ye çevirdiği tespit edildi.

Terk edilmiş bir barut deposunun tavanında, bir örümcek leşiyle bütünleşmiş halde bulunan sıra dışı bir oluşum, bilim insanlarını yeni bir türün keşfine götürdü. BBC Winterwatch çekimleri sırasında tesadüfen fark edilen bu yapı, sıradan bir ölümden ziyade, bir “zombi” istilasının kanıtı niteliğinde.

David Attenborough’un Adı Bir “Zombi” Mantarında Yaşayacak
Uluslararası Tarım ve Biyobilim Merkezi’nden mikolog Harry Evans ve ekibi, bulunan örneğin tamamen yeni bir tür olduğunu saptadı. Bilim dünyasına “Gibellula attenboroughii” ismiyle tanıtılan bu mantar, adını efsanevi doğa belgeselcisi Sir David Attenborough’dan alıyor. Ancak bu mantarın doğası, Attenborough’un belgesellerindeki huzurlu görüntülerden oldukça uzak.

Doğal Davranışları Tersine Çeviren “Zombi” Etkisi
Araştırmanın en çarpıcı kısmı, mantarın ev sahibi örümcek üzerindeki manipülatif gücü. Genellikle kuytu yerlerde saklanarak avlanan mağara örümcekleri (Metellina merianae ve Meta menardi), enfekte olduklarında alışılmışın dışına çıkıyorlar. Güvende hissettikleri ağlarını terk edip, mağaraların veya yapıların tavanı gibi en görünür noktalara tırmanıyorlar.
Bilim insanlarına göre bu bir tesadüf değil; mantarın hayatta kalma stratejisi. Yüksek ve hava akımına açık noktalarda can veren örümcekler, mantar sporlarının rüzgarla çok daha geniş alanlara yayılmasını sağlıyor. Bu durum, Brezilya ormanlarında karıncaları kontrol eden meşhur Ophiocordyceps mantarlarının yarattığı zombi davranışıyla büyük benzerlik taşıyor.

Tek Tür, Farklı Yüzler
Genetik analizler, barut depolarından ve mağaralardan alınan örneklerin aynı türe ait olduğunu doğruladı. Ancak mantarların görünümü, bulundukları ortama göre şaşırtıcı şekilde değişiyor. Örneğin:

Havasız ve Karanlık Alanlar: Mantar sporları sütun benzeri yapılar oluşturuyor ve ışık yokluğu nedeniyle renk pigmentlerini kaybediyor.

Aydınlık ve Hava Akımı Olan Alanlar: Sporlar daha dağınık ve klasik mantar formuna daha yakın sergileniyor.

Britanya’nın Gizli Çeşitliliği
Araştırmacılar, benzer vakaların Galler’de de görüldüğünü belirtiyor. Kaya çatlaklarını terk edip yosunların üzerinde ölüme yatan örümcekler, bu zombi mantarın Britanya Adaları’nda sanıldığından çok daha yaygın olabileceğini gösteriyor. Uzmanlar, literatürdeki eski çizimlerin birçoğunun aslında keşfedilmeyi bekleyen gizli Gibellula türleri olabileceğine inanıyor.
SAĞLIK
17 gün önceTÜRKİYE
17 gün önceTÜRKİYE
17 gün önceGÜNDEM
17 gün önceADLİ OLAYLAR
17 gün önceADLİ OLAYLAR
17 gün önceADLİ OLAYLAR
17 gün önce
1
Gıdada hile alarmı! Listeye 54 yeni ürün daha eklendi! Sucukta boya, lahmacunda kanatlı eti çıktı!
678 kez okundu
2
Erdoğan: CHP’ye meydanı bırakmayacağız
440 kez okundu
3
Akaryakıta yeni zam kapıda! Tabelada değişim! İşte 31 Mart 2026 benzin, motorin fiyatı..
280 kez okundu
4
Turistleri darp edip yağmalayan çeteye operasyon! – En son haberler
253 kez okundu
5
Sivas’ta yolcu otobüsü kazası: 7 ölü, çok sayıda yaralı var
249 kez okundu
Veri politikasındaki amaçlarla sınırlı ve mevzuata uygun şekilde çerez konumlandırmaktayız. Detaylar için veri politikamızı inceleyebilirsiniz.